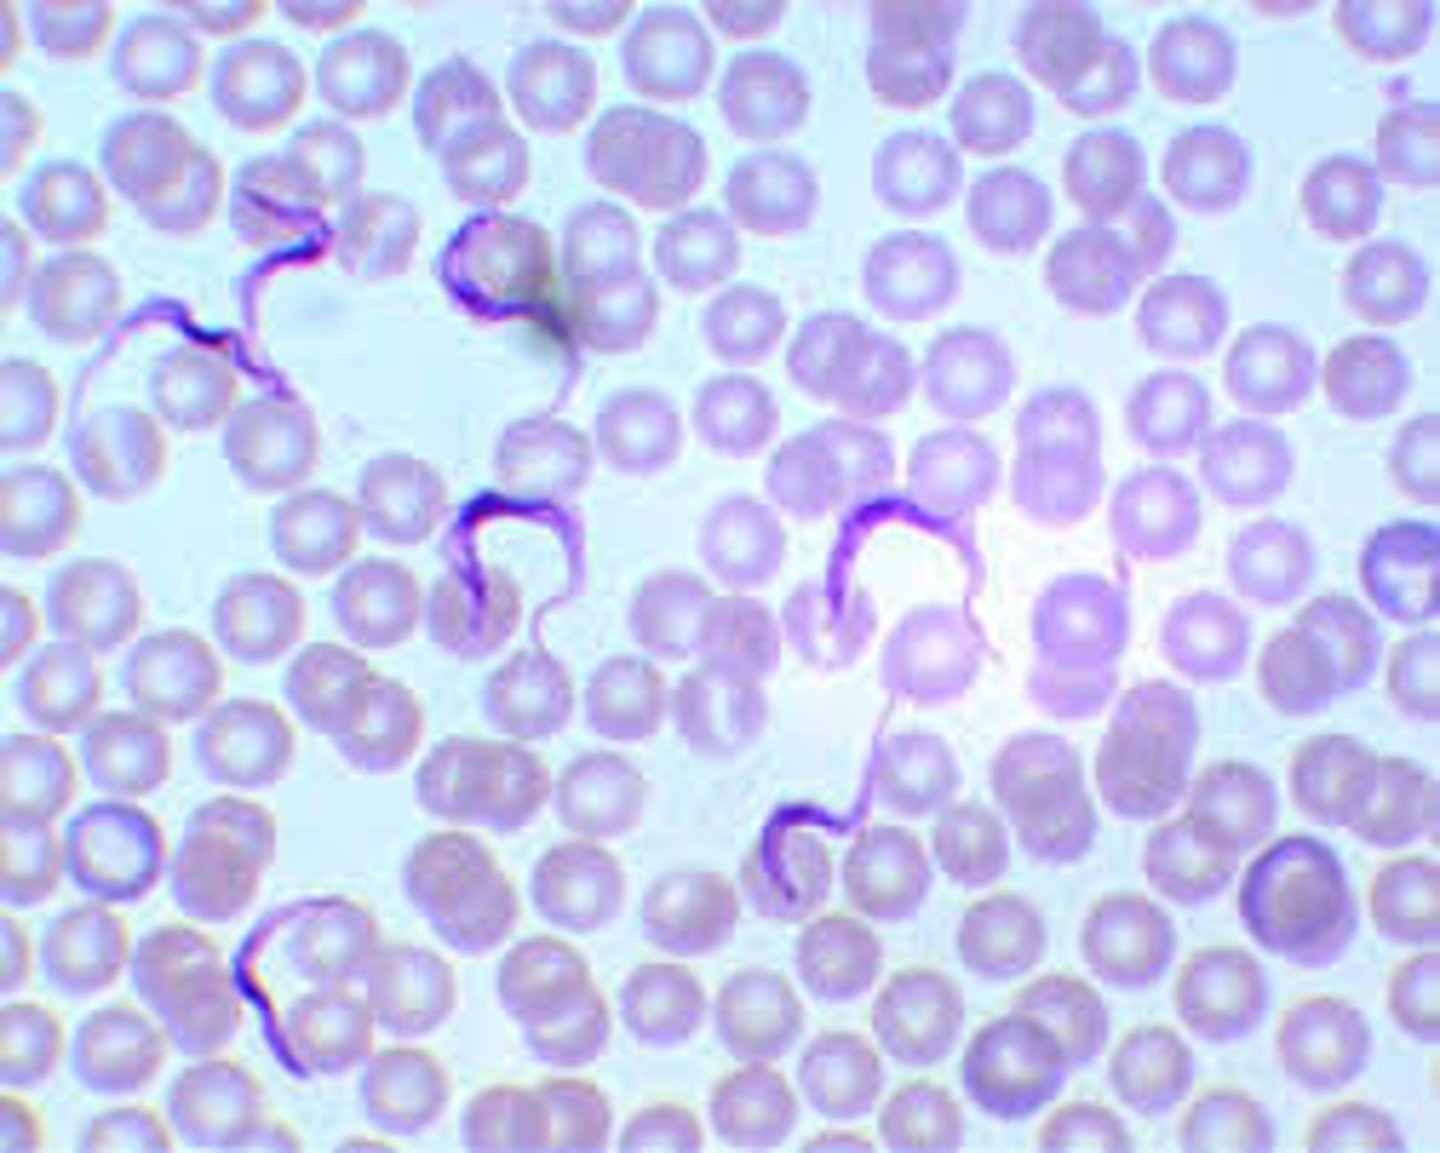
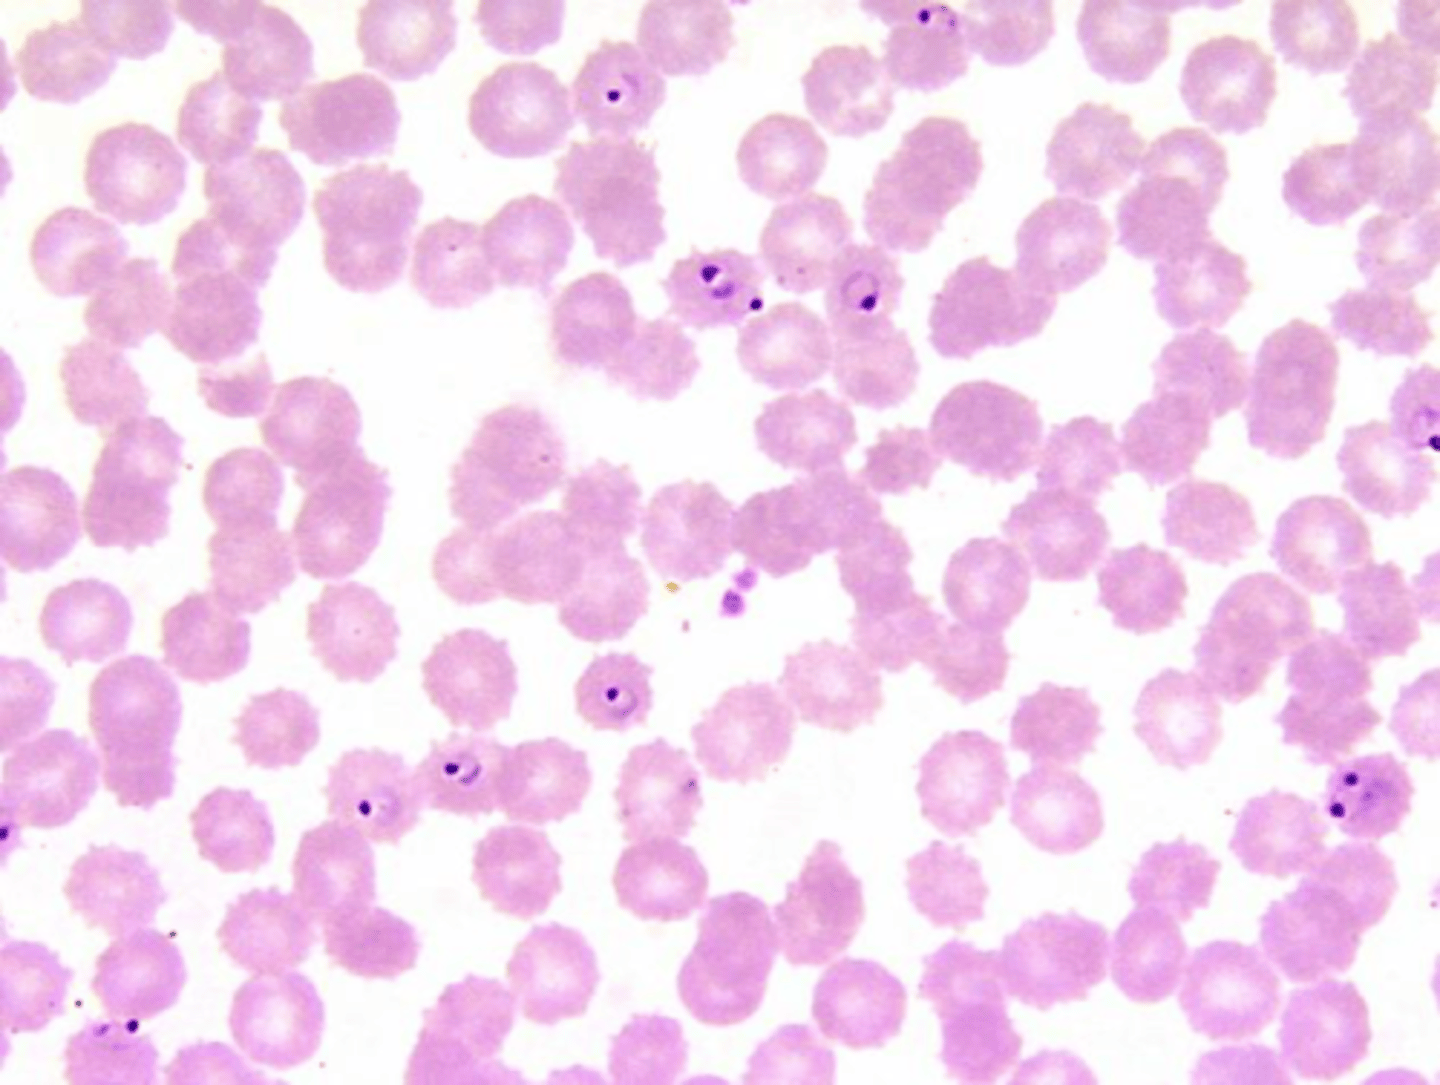
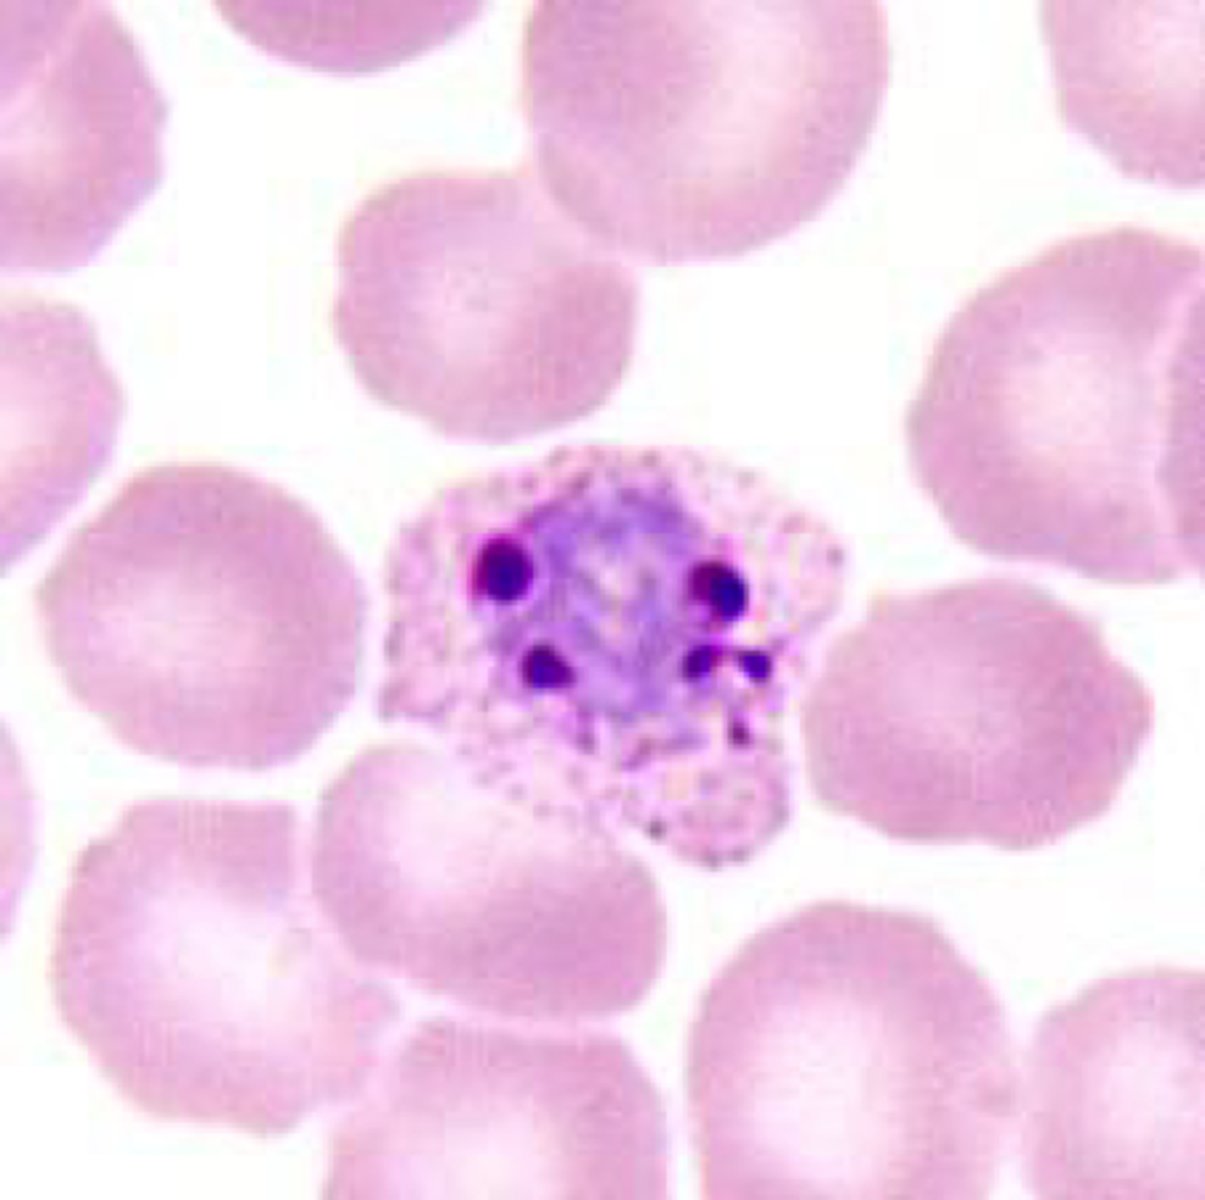
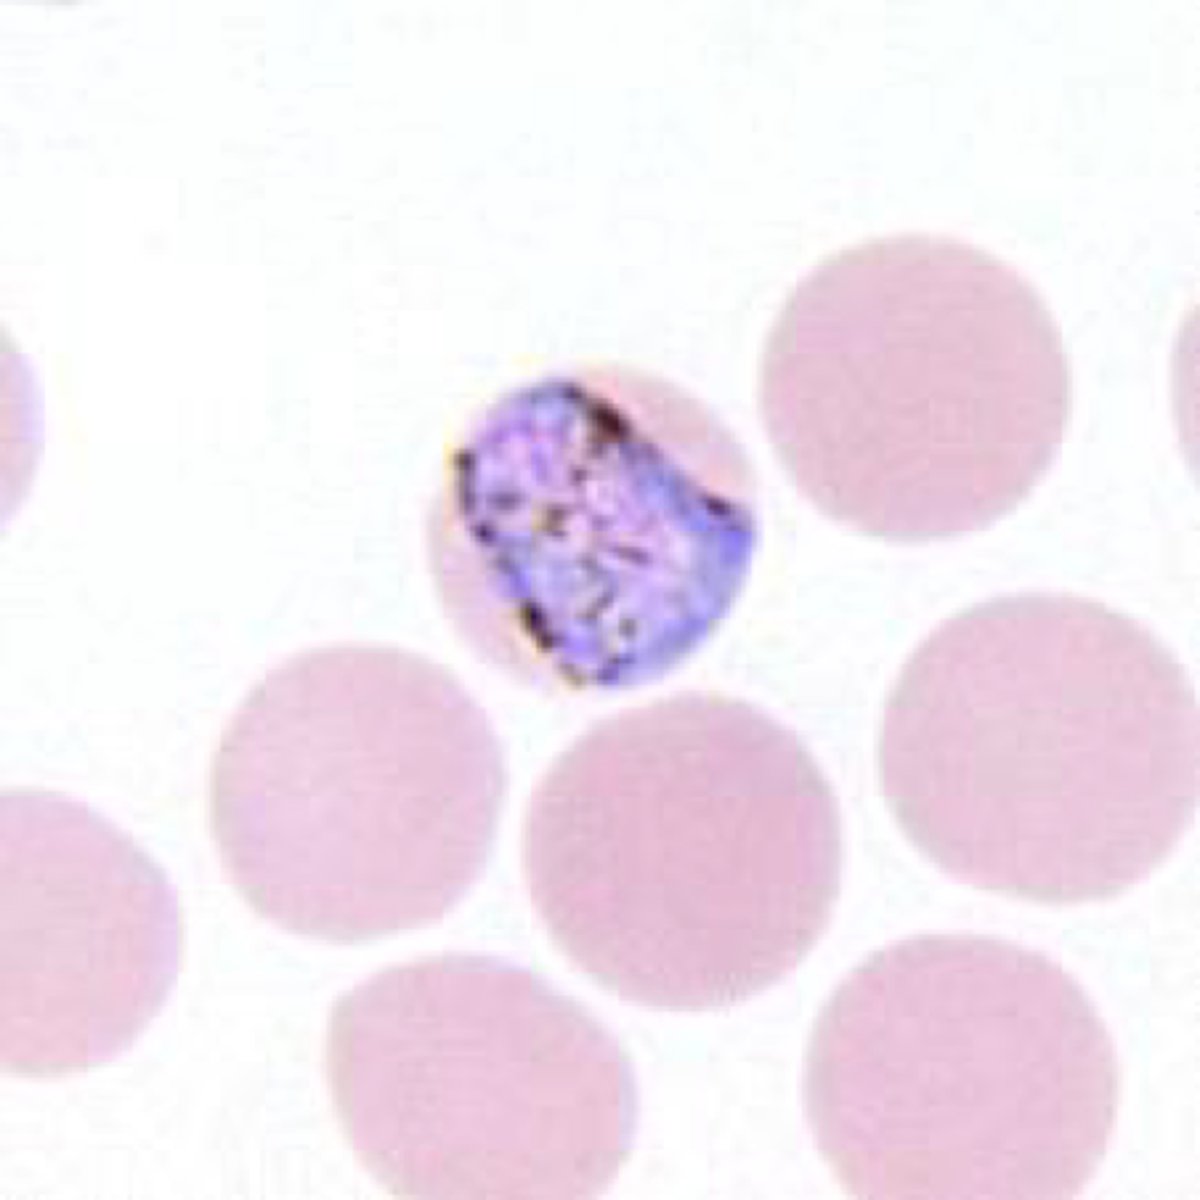
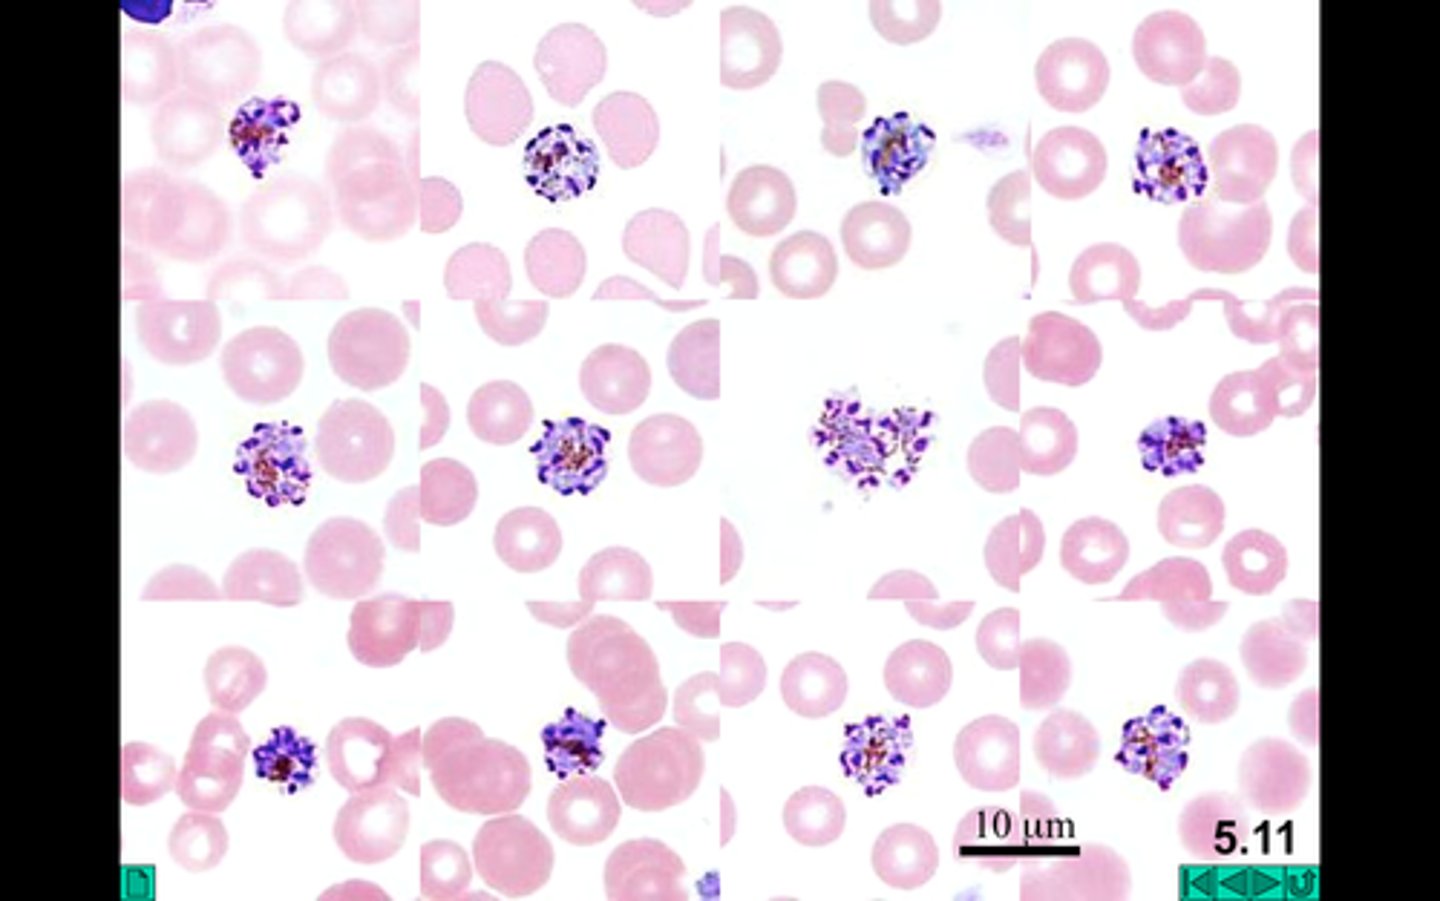
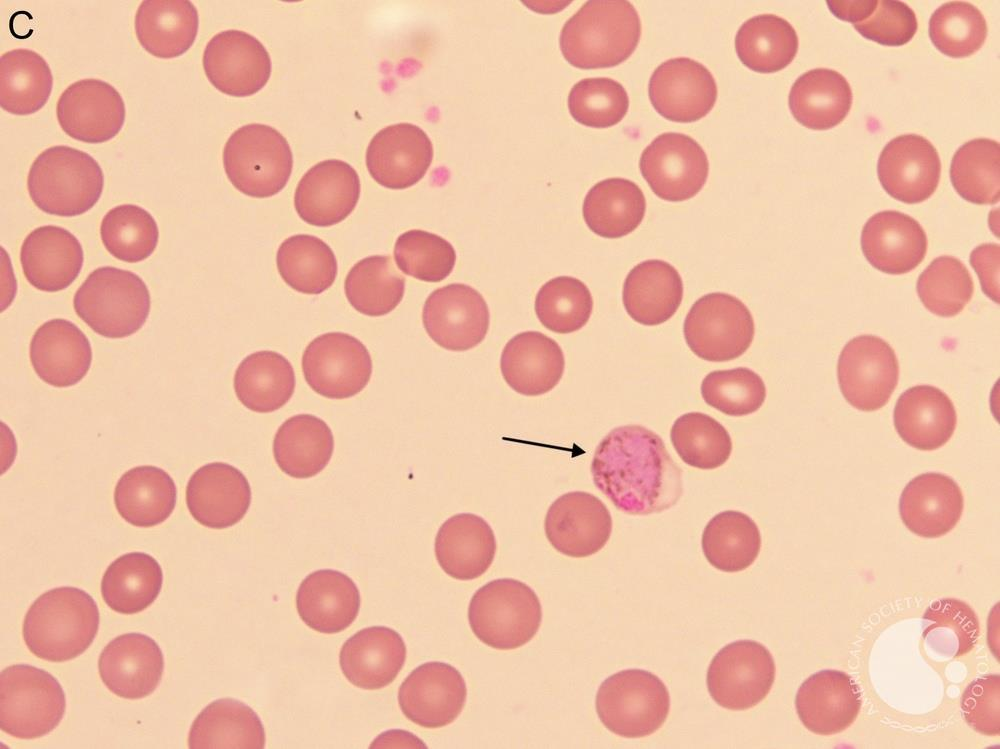

Parasitology Lab Exam 1
1/32
There's no tags or description
Looks like no tags are added yet.
Name | Mastery | Learn | Test | Matching | Spaced |
|---|
No study sessions yet.
33 Terms
Trypanosoma Brucei species (brucei, gambiense, rhodesiene)
Name the species

Trypanosoma Brucei - Trypomastigote
Name the stage and species
Tsetse fly (Glossina species)
T. Brucei species insect host

Trypanosoma cruzi - Trypomastigote
Name the stage and species

Trypanosoma cruzi - Amastigote
Name the stage and species

Reduviid Kissing bug
T. Cruzi insect host
(Fam. Reduviidae Subfam. Triatomiane)

Leishmania donovani - Amastigote
Name the stage and species

Leishmania donovani - Promastigote
elongated, mobile, and extracellular form of the Leishmania parasite found in the sand fly vector's midgut, characterized by a flagellum for motility, a nucleus, and a kinetoplast

Sandfly (Phlebotomus)
Vector of leishmania donovani

Chilomastix mesnili - Trophozoite
Name the stage and species

Chilomastix mesnili - Cyst
Name the stage and species

Giardia lamblia- Trophozoite
Name the stage and species

Giardia lamblia- Cyst
Name the stage and species

Trichomonas vaginalis - Trophozoite
Name the species and stage

Entamoeba histolytica - Trophozoite
Name the stage and species. NOTE: Nucleus with large central endosome with fine peripheral ring of chromatin. Also, note the large cytoplasmic vacuoles.

Entamoeba histolytica - Cyst
Name the stage and species. NOTE: There are FOUR nuclei (not all are shown here) and the dark spot is chormatoidal bars with rounded ends.

Entamoeba coli - Trophozoite
Name the stage and species.
NOTE: Endosome eccentric and larger granules in the ring of peripheral chromatin. Also note how many more medium cytoplasmic vacuoles are present.

Entamoeba coli - Cyst
Name the stage and species.
NOTE: Note chromatoidal bars present in immature cyst with splintered ends (not shown here). And the presence of EIGHT nuclei.

Plasmodium species - Sporozoites
Name the stage and species

Plasmodium vivax - Trophozoite
Name the stage and species.

Plasmodium vivax - Schizont
Name the stage and species.
NOTE: 12-24 merozoites

Plasmodium falciparum - Trophozoite
Name the stage and species.
Plasmodium falciparum - Schizont
Name the stage and species.
NOTE: 20-24 merozoites

Plasmodium falciparum - gametes
Name the stage and species

Plasmodium ovale - Trophozoite
Name the stage and species.
NOTE: Oval shape

Plasmodium ovale - Schizont
Name the stage and species.
NOTE: 6-14 merozoites.
Plasmodium malariae - Trophozoite
Name the stage and species.
Plasmodium malariae - Schizont
Name the stage and species.
NOTE: Note 6-12 merozoites around the cell.
Anopheles Mosquito
vectors of the parasite Plasmodium, a genus of protozoans that cause malaria in birds, reptiles, and mammals, including humans

Plasmodium pathology

Plasmodium vivax macrogametocyte
Plasmodium malariae macrogametocyte

plasmodium ovale macrogametocyte
